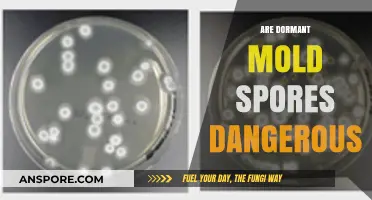
Dormant Mold Spores: Hidden Health Risks and Safety Concerns

Conidia, often referred to as asexual spores, are produced by fungi through a process called asexual reproduction, specifically via mitosis. Unlike sexual spores, which result from the fusion of gametes and genetic recombination, conidia are formed directly from the vegetative hyphae of the fungus without the involvement of a sexual cycle. This distinction is crucial because it highlights the primary method of reproduction for many fungi, allowing them to rapidly propagate in favorable conditions. While conidia are not sexual spores, they play a significant role in the dispersal and survival of fungal species, raising questions about their evolutionary advantages and ecological importance compared to sexual reproduction. Understanding the nature of conidia helps clarify their role in fungal life cycles and their impact on ecosystems and human activities, such as agriculture and medicine.
| Characteristics | Values |
|---|---|
| Nature of Conidia | Asexual spores |
| Formation Process | Produced through asexual reproduction (mitosis) |
| Genetic Composition | Haploid (contain a single set of chromosomes) |
| Function | Serve as dispersal and survival structures |
| Parent Organism | Typically fungi (e.g., molds, some mushrooms) |
| Sexual vs. Asexual | Conidia are asexual; sexual spores (e.g., asci, basidiospores) are produced via meiosis |
| Dispersal Mechanism | Released into the environment (air, water, surfaces) |
| Germination | Can germinate directly into new mycelium under favorable conditions |
| Examples of Producers | Aspergillus, Penicillium, Fusarium |
| Ecological Role | Contribute to fungal propagation and colonization |
Explore related products
What You'll Learn
- Conidia Formation Process: Asexual reproduction via conidiogenesis, producing single-celled spores without gamete fusion
- Sexual vs. Asexual Spores: Conidia are asexual; sexual spores involve gamete fusion (e.g., zygospores)
- Conidia Function: Dispersal and survival structures, not involved in sexual reproduction
- Fungal Life Cycles: Conidia in asexual phase; sexual spores in alternation of generations
- Genetic Variation: Conidia are clones; sexual spores increase diversity via recombination

Conidia Formation Process: Asexual reproduction via conidiogenesis, producing single-celled spores without gamete fusion
Conidia, often mistaken for sexual spores, are exclusively products of asexual reproduction. This process, known as conidiogenesis, occurs in fungi like *Aspergillus* and *Penicillium*, where specialized structures called conidiophores develop at their tips or sides. Unlike sexual spores, which result from gamete fusion, conidia form through mitotic cell division, ensuring genetic uniformity with the parent organism. This asexual method allows rapid proliferation under favorable conditions, making conidia a key survival mechanism for many fungal species.
The formation of conidia begins with the differentiation of conidiogenous cells, which undergo repeated divisions to produce chains or clusters of spores. These spores are single-celled, non-motile, and often lightweight, facilitating dispersal by air or water. For instance, *Aspergillus niger* produces conidia in dense, dark masses, while *Penicillium* forms brush-like structures. Practical observation of this process can be achieved by culturing these fungi on agar plates at 25°C for 5–7 days, where conidiophores and conidia become visible under a 40x microscope.
One critical advantage of conidia is their resilience. They can survive harsh conditions, such as desiccation or nutrient scarcity, acting as dormant propagules until environmental conditions improve. This adaptability is particularly evident in agricultural settings, where conidia of *Fusarium* species persist in soil for years, posing risks to crop health. To mitigate this, farmers often employ fungicides like tebuconazole at a dosage of 0.5–1.0 L/ha, targeting conidia before they germinate and infect plants.
Comparatively, sexual spores (e.g., zygospores or ascospores) involve genetic recombination, offering diversity but requiring more energy and specific conditions. Conidia, in contrast, are a streamlined solution for rapid colonization. For hobbyists or educators, demonstrating conidiogenesis in a classroom setting can be done by inoculating potato dextrose agar with *Penicillium* spores and observing the growth over a week, highlighting the efficiency of asexual reproduction.
In conclusion, the conidia formation process exemplifies nature’s ingenuity in balancing speed and survival. By bypassing the complexities of sexual reproduction, fungi ensure their persistence across diverse environments. Understanding this mechanism not only clarifies the distinction between sexual and asexual spores but also informs strategies for managing fungal pathogens in agriculture and medicine. Whether in a lab or field, recognizing conidiogenesis underscores the adaptability of microbial life.
How Long Do Ringworm Spores Survive: A Comprehensive Guide
You may want to see also

Sexual vs. Asexual Spores: Conidia are asexual; sexual spores involve gamete fusion (e.g., zygospores)
Conidia, often observed in fungi like *Aspergillus* and *Penicillium*, are asexual spores produced through mitosis, a process that does not involve the fusion of gametes. This distinguishes them fundamentally from sexual spores, which arise from the union of haploid cells, such as in the formation of zygospores in fungi like *Rhizopus*. Understanding this distinction is crucial for fields like mycology, agriculture, and medicine, where the reproductive mechanisms of fungi directly impact their spread, pathogenicity, and control.
To illustrate, consider the lifecycle of *Aspergillus fumigatus*. When conditions are favorable, it produces conidia on specialized structures called conidiophores. These spores disperse through air, water, or soil, germinating rapidly to colonize new environments. In contrast, sexual spores like zygospores form only under specific conditions, such as nutrient limitation or stress, and require the compatibility of mating types. For instance, in *Rhizopus*, zygospores develop after the fusion of gametangia, resulting in a thick-walled, dormant structure capable of surviving harsh conditions. This sexual process enhances genetic diversity, a key advantage over the clonal reproduction of conidia.
From a practical standpoint, distinguishing between sexual and asexual spores is essential for managing fungal diseases. Conidia, being asexual, spread rapidly and uniformly, making them primary agents of infections like aspergillosis. In agriculture, conidia from *Fusarium* species can devastate crops, necessitating fungicides like tebuconazole or prochloraz at recommended dosages (e.g., 0.5–1.0 L/ha for tebuconazole). Sexual spores, while less common, pose risks due to their genetic variability, which can lead to fungicide resistance. For example, zygospores of *Rhizopus* can survive soil treatments, re-emerging when conditions improve.
A comparative analysis reveals the trade-offs between these reproductive strategies. Asexual spores like conidia offer speed and efficiency, enabling fungi to exploit resources quickly. However, their lack of genetic diversity limits adaptability. Sexual spores, though slower to produce, provide evolutionary advantages by shuffling genetic material, which is critical for long-term survival in changing environments. This duality underscores the importance of targeted interventions: controlling conidia through sanitation and fungicides, while monitoring for sexual reproduction in persistent infections or infestations.
In conclusion, while conidia dominate fungal dispersal due to their asexual, rapid production, sexual spores like zygospores play a vital role in genetic resilience. Recognizing these differences allows for more effective management strategies, whether in clinical settings, agriculture, or environmental studies. For instance, in hospitals, HEPA filtration reduces conidial spread, while in fields, crop rotation disrupts the lifecycle of both asexual and sexual spores. By tailoring approaches to the specific reproductive mechanisms, we can mitigate the risks posed by these microscopic powerhouses.
Do Gram-Negative Bacteria Form Spores? Unraveling the Survival Mechanisms
You may want to see also

Conidia Function: Dispersal and survival structures, not involved in sexual reproduction
Conidia, often mistaken for sexual spores, are asexual structures produced by fungi to ensure their survival and dispersal. Unlike sexual spores, which result from genetic recombination, conidia are formed through mitosis, retaining the genetic identity of the parent organism. This asexual nature is a key distinction, as it allows fungi to rapidly colonize new environments without the need for a mate. For instance, when a fungus like *Aspergillus* produces conidia, these structures are genetically identical to the parent, enabling quick proliferation under favorable conditions.
Consider the lifecycle of a fungus in a decaying log. As resources deplete, the fungus generates conidia, which are lightweight and often equipped with structures like wings or hydrophobic surfaces to aid in wind or water dispersal. This mechanism ensures that the fungus can spread to new nutrient-rich areas, even if the parent organism perishes. Practical applications of this knowledge include controlling fungal growth in agricultural settings by disrupting conidial dispersal, such as using fungicides or physical barriers to prevent airborne spread.
From a survival perspective, conidia are remarkably resilient. They can withstand harsh conditions, including desiccation, UV radiation, and temperature extremes, thanks to their thick cell walls and protective pigments. For example, *Cladosporium* conidia can remain dormant for years, only germinating when conditions become favorable. This adaptability makes conidia essential for fungal persistence in diverse ecosystems, from soil to human-made environments like HVAC systems. To mitigate fungal contamination indoors, maintaining low humidity (below 60%) and regular cleaning of surfaces can inhibit conidial germination.
Comparatively, sexual spores, such as asci or basidiospores, are less common and require more energy to produce due to the complexities of meiosis and mating. Conidia, however, are the workhorses of fungal dispersal, allowing species to thrive in dynamic environments. For gardeners, understanding this distinction is crucial: while sexual spores might introduce genetic diversity, conidia are the primary culprits in rapid fungal spread, such as powdery mildew on plants. Using fungicides targeting conidial germination can effectively manage outbreaks.
In summary, conidia serve as fungi’s primary tools for dispersal and survival, not sexual reproduction. Their asexual nature, combined with durability and efficient dispersal mechanisms, ensures fungal persistence across environments. By recognizing their role, we can develop targeted strategies to control unwanted fungal growth, whether in agriculture, indoor spaces, or natural ecosystems. This knowledge underscores the importance of distinguishing between sexual and asexual spores in both scientific research and practical applications.
How Mold Spores Feed: Unveiling Their Unique Survival Strategies
You may want to see also
Explore related products

Fungal Life Cycles: Conidia in asexual phase; sexual spores in alternation of generations
Fungi exhibit a fascinating alternation of generations, a lifecycle that toggles between asexual and sexual phases. In the asexual phase, conidia—single-celled, haploid spores—are produced through mitosis. These spores are the workhorses of fungal dispersal, capable of surviving harsh conditions and colonizing new environments rapidly. For example, *Aspergillus* and *Penicillium* genera rely heavily on conidia for propagation, which are dispersed through air, water, or insects. This phase is efficient for quick multiplication but lacks genetic diversity, a limitation fungi address in their sexual phase.
The sexual phase introduces genetic recombination, a critical mechanism for adaptation and survival. Here, fungi produce sexual spores such as asci or basidiospores, which result from the fusion of haploid gametes (e.g., through karyogamy in dikaryotic hyphae). This process occurs under specific environmental triggers, such as nutrient scarcity or temperature shifts. For instance, *Neurospora crassa* undergoes sexual reproduction when exposed to prolonged darkness and limited nitrogen. Sexual spores are more resilient than conidia, often surviving extreme conditions like freezing temperatures or desiccation, making them ideal for long-term survival.
Comparing the two phases highlights their complementary roles. Conidia dominate in stable, resource-rich environments where rapid colonization is advantageous. Sexual spores, however, are produced in response to stress, ensuring genetic diversity to combat changing conditions. This alternation of generations is not just a survival strategy but a testament to fungal evolutionary sophistication. For gardeners or farmers, understanding this cycle can inform practices like crop rotation or fungicide application timing to disrupt asexual spore production.
Practical applications of this knowledge extend to biotechnology and medicine. Conidia are used in industrial fermentation processes, such as producing enzymes or biofuels, due to their rapid growth. Conversely, sexual spores are studied for their role in pathogenic fungi, like *Magnaporthe oryzae*, which causes rice blast. By targeting the sexual phase, researchers aim to develop fungicides that prevent spore formation, reducing disease spread. For hobbyists cultivating mushrooms, inducing the sexual phase through controlled humidity and light can yield more diverse and resilient strains.
In conclusion, the fungal lifecycle’s alternation between conidia and sexual spores is a masterclass in adaptability. While conidia ensure rapid propagation, sexual spores provide genetic innovation. Recognizing these phases allows for targeted interventions, whether in agriculture, industry, or research. For instance, maintaining optimal moisture levels (50-70% humidity) can suppress conidia formation in indoor plants, while specific temperature shifts (e.g., 25°C to 15°C) can induce sexual reproduction in lab settings. This dual strategy ensures fungi thrive across ecosystems, offering lessons in resilience and resourcefulness.
Are Bacterial Spores Resistant to Antibiotics? Unraveling the Mystery
You may want to see also

Genetic Variation: Conidia are clones; sexual spores increase diversity via recombination
Conidia, the asexual spores produced by fungi, are essentially clones of the parent organism. This means they carry the same genetic material, offering no opportunity for genetic recombination. In contrast, sexual spores, such as asci or basidiospores, arise from the fusion of gametes, introducing genetic diversity through the shuffling of DNA. This fundamental difference highlights the role of conidia in rapid proliferation and survival under stable conditions, while sexual spores are key to adaptation and evolution in changing environments.
Consider the lifecycle of *Aspergillus fumigatus*, a common mold. When conditions are favorable, it produces conidia en masse, allowing it to colonize new territories quickly. However, if the environment shifts—say, due to nutrient scarcity or temperature changes—the fungus may engage in sexual reproduction, forming cleistothecia that release genetically diverse ascospores. This dual strategy ensures both immediate survival and long-term resilience. For researchers studying fungal pathogens, understanding this distinction is critical: conidia dominate in infections, but sexual spores may emerge under stress, complicating treatment.
From a practical standpoint, the clonal nature of conidia has implications for agriculture and medicine. In crop protection, fungicides targeting conidia-producing fungi must account for their rapid spread but uniform genetic makeup. For instance, a single genetic mutation conferring resistance can quickly dominate a population, rendering the fungicide ineffective. Conversely, sexual spores’ genetic diversity means resistance evolves more slowly, as recombination dilutes the spread of any single advantageous trait. Farmers can mitigate this by rotating fungicides and promoting environmental conditions that discourage conidia production.
A persuasive argument for the importance of sexual spores lies in their role in combating fungal diseases. Take *Candida albicans*, a human pathogen that primarily reproduces asexually but can undergo sexual reproduction under specific conditions. Studies show that sexual spores of *C. albicans* exhibit increased virulence and drug resistance due to genetic recombination. Clinicians must recognize this potential shift, especially in persistent infections, to adjust treatment strategies accordingly. Encouraging sexual reproduction in lab settings could even help predict emerging resistance patterns.
Finally, a comparative analysis underscores the evolutionary trade-offs between conidia and sexual spores. Conidia’s clonal efficiency is ideal for exploiting stable, resource-rich environments, as seen in *Penicillium* molds colonizing bread. Sexual spores, however, are the ace up fungi’s sleeve for unpredictable habitats, such as soil or decaying matter, where genetic diversity enhances survival. This duality explains why most fungi retain both reproductive modes, balancing immediate success with long-term adaptability. For ecologists, this insight frames fungi as master strategists, tailoring their reproduction to the demands of their environment.
Unveiling the Fascinating World of Spores: Reproduction Secrets Explained
You may want to see also
Frequently asked questions
No, conidia are asexual spores produced by fungi through mitosis, not meiosis, and do not involve the fusion of gametes.
Conidia are asexually produced and genetically identical to the parent fungus, while sexual spores (like asci or basidiospores) result from meiosis and genetic recombination.
Yes, conidia can germinate and grow into a new fungus independently, as they are asexual structures and do not require fertilization.
No, only certain groups of fungi, such as molds (e.g., Aspergillus, Penicillium), produce conidia; other fungi rely on sexual or different asexual methods for reproduction.